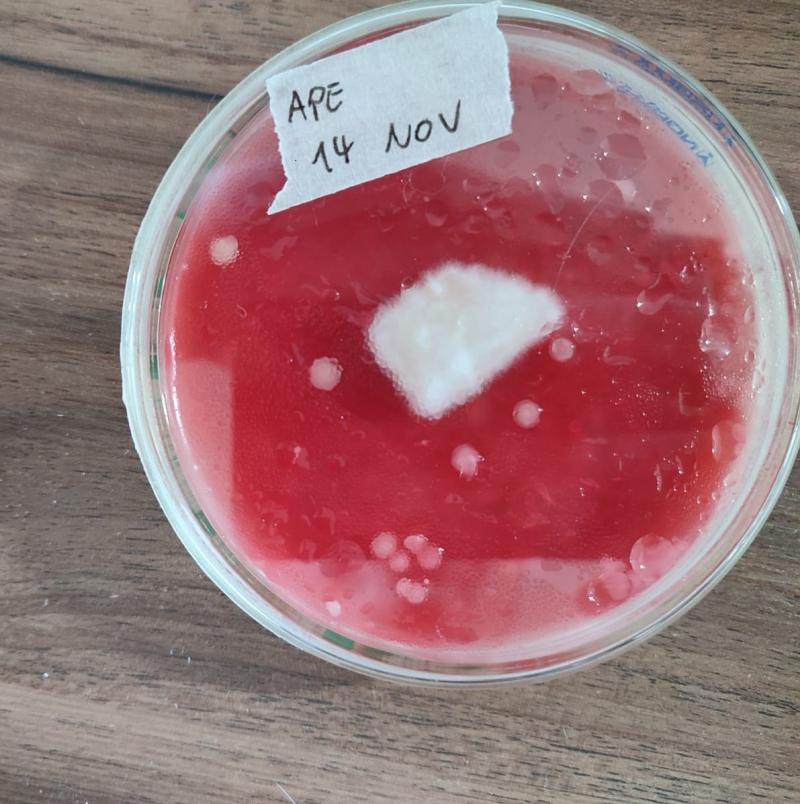
/forum/uploads/images/1700/402891051_10230682939321015_7368844587902666985.jpg

- SillyCone

Ex-penseur de conscience
- 19 novembre 2023 à 13:05
Anonyme 239 a écrit
Tu les réduis en poudre et avaler avec un verre d'eau.
Oh merci, j'y avais jamais pensé...
C'est con, après 30 ans de champis, j'aurais dû expérimenté un peu !
Je ne réponds pas aux demandes d'information par MP.
Faites les en public que tout le monde puisse y répondre.
Gratitude
Hors ligne

- Mezko

Nouveau Psycho
- 19 novembre 2023 à 14:12

*o*
Hors ligne

- Doromo

Nouveau Psycho - 20 novembre 2023 à 20:23
Mezko a écrit
Je vais profiter de l'après midi pour refaire de la CL et de l'agar pour les cubensis
Attention pente glissante, on sait où ça commence mais pas où ça s'arrête ^^
Et vos histoires du monde shamanique sont drolatiquement passionnantes.
D'ailleurs, vu que vous en parliez et maintenant que j'ai quelques envolées au psilohuasca sous la ceinture, je dois dire, c'est vraiment zarbi la façon dont ça modifie les visuels et l'ambiance générale. On dirait de la DMT déliquescente.
Dernière modification par Doromo (20 novembre 2023 à 20:26)
Quand on a rien dans l'ciboulot
autant y mettre un gros bédo
Hors ligne

- Mezko

Nouveau Psycho
- 20 novembre 2023 à 21:12
Doromo a écrit
Attention pente glissante, on sait où ça commence mais pas où ça s'arrête ^^
Et vos histoires du monde shamanique sont drolatiquement passionnantes.
D'ailleurs, vu que vous en parliez et maintenant que j'ai quelques envolées au psilohuasca sous la ceinture, je dois dire, c'est vraiment zarbi la façon dont ça modifie les visuels et l'ambiance générale. On dirait de la DMT déliquescente.
Hahaha, dis toi que je voulais écrire un bouquin là dessus histoire de dézinguer du monde mais finalement, je suis trop fainéant pour un truc aussi inintéressant...mais qui sait !
Je suis très curieux de ces histoires de psilohuasca, c'est ici que j'ai lu le terme pour la première fois et j'y pense de temps à autres. Tout comme retourner voir du côté de la liane...
En parallèle, je lance le grain ce soir. Et je pense avoir déjà merdé: j'en ai trop mis 
*o*
Hors ligne

- Mezko

Nouveau Psycho
- 21 novembre 2023 à 09:12

Des taches marrons un peu gluantes.
*o*
Hors ligne

- Doromo

Nouveau Psycho - 24 novembre 2023 à 18:52
Mezko a écrit
Quelqu'un saurait me dire de quel genre de contamination cette plaque d'agar est victime? Pas la mienne mais j'ai le même genre et ça revient sur pas mal de transfert
Alors là mon gars… faudrait appeler un bactériologue équipé d'un bon microscope et de sacrées connaissances. En tout cas ça dépasse mes compétences.
Enfin, je pense que c'est de la bactérie, elles aiment se montrer gluantes et en relief. Les quelques contas champignonesques auxquelles j'ai eu droit restaient très discrètes avant de sporuler vert d'un seul coup, ou exhibaient leur mycoïdie dès le départ.
Ça n'a pas grande importance de toute façon, une conta est une conta, t'en a des millions-exposant-au-pif, et à de très rares exceptions près, ça signifie direct poubelle (ou mieux, fond de jardin). Surtout sur l'agar, ça vaut vraiment pas le coup de contaminer du grain ou une LC avec. A la rigueur, du grain bactérié, ça peut donner et ça coute pas grand chose de l'accoucher, mais au moindre doute sur agar, c'est adieux.
T'en a peut-être parlé plus tôt, mais tu pourrais nous décrire tes techniques stériles quand tu bosses sous boite ? Parfois, il faut pas grand chose pour drastiquement augmenter le taux de succès.
Hahaha, dis toi que je voulais écrire un bouquin là dessus histoire de dézinguer du monde mais finalement, je suis trop fainéant pour un truc aussi inintéressant...mais qui sait !
Franchement, ce serait une super toile narrative de fond, surtout basé sur du vécu. Change les noms, romance un peu, injecte ton style, et ce sera certainement plus intéressant que 90% des primés au nobel.
"Je suis très curieux de ces histoires de psilohuasca, c'est ici que j'ai lu le terme pour la première fois et j'y pense de temps à autres."
Je te conseille d'essayer, c'est assez surprenant. Je le fais rarement cela dit, ça rend mes chachas tout méconnaissables, et leur effet kinesthésio-dynamisant (mon préféré!) disparait en grande partie au profit d'effets plus enthéogéniques et sédatifs qui, honnêtement, me vont pendant 20 minutes de changa, mais ont tôt fait de me saouler après une heure ou deux.
Le trip est effectivement beaucoup plus stable, comme disait Sillycone. Et avec des harmalas bien épurés (pas ceux que j'extrais moi-même, donc ^^), l'effet de dissolution corporelle est assez dingue.
Je trouve l'ambiance plus "sérieuse", aussi, genre Grand Archevêque Sylvestre tout guindé sur sa chaire ligneuse, se retenant de péter sur l'assemblée en contre-bas.
Un trip emphatique.
En parallèle, je lance le grain ce soir. Et je pense avoir déjà merdé: j'en ai trop mis
Tu peux remplir tes pots très haut si t'as envie, ça gênera pas Mymy. Tu risques de galérer un peu à mélanger le grain en début de colo par succussion si tu manques d'espace en haut, mais ça se fait quand même.
(et si tu parlais d'en avoir trop mis dans ta marmite préparatoire, franchement osef, fais plus de pots)
Dernière modification par Doromo (24 novembre 2023 à 19:01)
Quand on a rien dans l'ciboulot
autant y mettre un gros bédo
Hors ligne

- SillyCone

Ex-penseur de conscience
- 25 novembre 2023 à 00:32
Mezko a écrit
Je suis très curieux de ces histoires de psilohuasca, c'est ici que j'ai lu le terme pour la première fois et j'y pense de temps à autres. Tout comme retourner voir du côté de la liane...
La psilohuasca, pour moi, c'est le meilleur des 2 mondes : l'effet champi transformé par l'harmaline sans les effets vomitifs de la madre.
Les visions du champis aussi évoluent dans la direction de la DMT pure mais sans les entités (pour moi, hein).
Mais je mets relativement peu d'harmaline, entre 75 et 100mg, l'équivalent de max 2g de rue. Plus et ça devient plus ardu, ça vibre de partout, et la nausée est pas loin.
Ça peut rendre le trip plus se(ns/x)uel aussi.
Dernière modification par SillyCone (25 novembre 2023 à 00:32)
Je ne réponds pas aux demandes d'information par MP.
Faites les en public que tout le monde puisse y répondre.
Gratitude
Hors ligne
Le mieux est d'acheter une seringue de spore ou un kit de copelandia pour mettre avec les ingrédients de base dans la barquette?
Hors ligne

- Mezko

Nouveau Psycho
- 26 novembre 2023 à 11:37
Doromo a écrit
T'en a peut-être parlé plus tôt, mais tu pourrais nous décrire tes techniques stériles quand tu bosses sous boite ? Parfois, il faut pas grand chose pour drastiquement augmenter le taux de succès.
Alors, pour le moment, c'est très rudimentaire. J'ai cette boite:
J'ai retiré les gants parce que pas pratiques du tout (leur texture était très glissante et je ne pouvais pas réellement manipuler les éléments dans la boite). Désormais, j'utilise de simple gants sur lesquels je mets de la solution hydro-alcoolique. Je me désinfecte les mains et les avant bras aussi, et je mets un masque sur le visage. A l'intérieur de la boite, avant d'ouvrir quoi que ce soit, je pulvérise avec un spray d'alcool isopropylique à 70% ou un spray de javel diluée.
J'ai un scalpel que je désinfecte à l'alcool et je passe la lame sous un briquet chalumeau jusqu'à ce qu'elle soit rouge. Pour gratter les spores dans, j'utilise une petite boucle d'inoculation que je chauffe au chalumeau également. L'eau que j'ai utilisée pour faire mes seringues de spores a été distillée + passée à l'autoclave pendant 20 minutes (avec la CL et l'agar).
Doromo a écrit
Franchement, ce serait une super toile narrative de fond, surtout basé sur du vécu. Change les noms, romance un peu, injecte ton style, et ce sera certainement plus intéressant que 90% des primés au nobel.
Ca reste dans un coin de ma tête mais je ne me sens pas d'y revenir tant que je ne suis pas retourner faire coucou à l'ayahuasca (ça doit faire 13 ans que je n'ai pas fait de cérémonie).
Doromo a écrit
"Je suis très curieux de ces histoires de psilohuasca, c'est ici que j'ai lu le terme pour la première fois et j'y pense de temps à autres."
Je te conseille d'essayer, c'est assez surprenant. Je le fais rarement cela dit, ça rend mes chachas tout méconnaissables, et leur effet kinesthésio-dynamisant (mon préféré!) disparait en grande partie au profit d'effets plus enthéogéniques et sédatifs qui, honnêtement, me vont pendant 20 minutes de changa, mais ont tôt fait de me saouler après une heure ou deux.
Le trip est effectivement beaucoup plus stable, comme disait Sillycone. Et avec des harmalas bien épurés (pas ceux que j'extrais moi-même, donc ^^), l'effet de dissolution corporelle est assez dingue.
Je trouve l'ambiance plus "sérieuse", aussi, genre Grand Archevêque Sylvestre tout guindé sur sa chaire ligneuse, se retenant de péter sur l'assemblée en contre-bas.
Un trip emphatique.
Miam, ça donne envie. J'imagine que l'occasion finira par se présenter ! Je ne cours pas après mais j'ai toujours une oreille attentive aux opportunités qui se baladent 
Merci pour les détails !
Doromo a écrit
Tu peux remplir tes pots très haut si t'as envie, ça gênera pas Mymy. Tu risques de galérer un peu à mélanger le grain en début de colo par succussion si tu manques d'espace en haut, mais ça se fait quand même.
(et si tu parlais d'en avoir trop mis dans ta marmite préparatoire, franchement osef, fais plus de pots)
J'ai bazardé une grande partie du grain que j'avais lancé et j'en ai refait, dans une quantité plus limitée. Le gâchis me fait chier, mais j'étais dépassé par la place que ça allait prendre (mon autoclave de 23l était quasiment rempli jusqu'à ras bord). J'en ai relancé et j'ai pu faire 2 pots d'un litre, 2 pots de 1,5l et deux pots de 250ml (qui vont me permettre de tester mes CL, mais je crois qu'aucune n'est bonne. J'ai fini par mettre un des mycélium qui se développait bien dans l'agar mais qui, au bout d'une semaine, s'est avéré contaminé (à une distance raisonnable de la partie saine).
SillyCone a écrit
La psilohuasca, pour moi, c'est le meilleur des 2 mondes : l'effet champi transformé par l'harmaline sans les effets vomitifs de la madre.
Les visions du champis aussi évoluent dans la direction de la DMT pure mais sans les entités (pour moi, hein).
Mais je mets relativement peu d'harmaline, entre 75 et 100mg, l'équivalent de max 2g de rue. Plus et ça devient plus ardu, ça vibre de partout, et la nausée est pas loin.
Ça peut rendre le trip plus se(ns/x)uel aussi.
Bravo à vous, vous m'avez bien saucé !
*o*
Hors ligne

- Doromo

Nouveau Psycho - 26 novembre 2023 à 19:12
Mezko a écrit
J'ai retiré les gants parce que pas pratiques du tout (leur texture était très glissante et je ne pouvais pas réellement manipuler les éléments dans la boite). Désormais, j'utilise de simple gants sur lesquels je mets de la solution hydro-alcoolique. Je me désinfecte les mains et les avant bras aussi, et je mets un masque sur le visage. A l'intérieur de la boite, avant d'ouvrir quoi que ce soit, je pulvérise avec un spray d'alcool isopropylique à 70% ou un spray de javel diluée.
J'ai un scalpel que je désinfecte à l'alcool et je passe la lame sous un briquet chalumeau jusqu'à ce qu'elle soit rouge. Pour gratter les spores dans, j'utilise une petite boucle d'inoculation que je chauffe au chalumeau également. L'eau que j'ai utilisée pour faire mes seringues de spores a été distillée + passée à l'autoclave pendant 20 minutes (avec la CL et l'agar).
C'est pas mal du tout. Après, vire le scotch, c'est typiquement le genre de truc qui va vibrer au niveau des coudes quand tu bosseras à l'intérieur, faisant entrer de l'air contaminé au moment même où tu réalises les actes à risques (ouverture de pot, découpe d'échantillon d'agar, etc). Arrange toi simplement pour que les ouvertures soient assez larges pour pouvoir travailler à l'intérieur sans frotter le plastique (des ouvertures) avec tes bras. La box permet de limiter les mouvements d'air par rapport à un travail à l'air libre, mais ce qui fait son efficacité, c'est les quelques secondes que tu prendras avant chaque geste risqué (pour laisser retomber les particules en suspension), la précision de tes gestes (le moins de mouvements inutiles possible, faire bien gaffe au placement de mains et des outils (éviter au maximum de se placer au dessus des pots et autres boites de pétri blabla)) ainsi que - et là c'est pour moi le gros avantage de la boite - la pellicule de liquide tapissant le plastique, laquelle piègera les nouveaux arrivants et leur évitera de rebondir vers tes champis (je pulvérise de l'eau savonneuse partout à l'intérieur à part au plafond, après la désinfection préparatoire, pour avoir une couche de gouttelettes fines qui me tiennent toute la séance). Et bien sûr, travaille le plus au fond de la boite possible.
Bien sûr, tout ça ne sert à rien si le grain ou l'agar n'a pas été suffisamment stérilisé, mais je ne t'apprends rien ^^
SillyCone a écrit
La psilohuasca, pour moi, c'est le meilleur des 2 mondes : l'effet champi transformé par l'harmaline sans les effets vomitifs de la madre.
En vrai, je pense que c'est effectivement un excellent moyen de donner un aperçu de la DMT à une personne naïve en la matière, et pas forcément très aventureuse, surtout si elle est de base très peu douée avec un briquet. Et j'essayerai avec moins d'harmalas la prochaine fois, je tourne toujours entre 250 et 300 mg, et je pense qu'avec les 7 gr de psilos par dessus, c'est un poil trop intense pour moi par moments.
Par contre, les redescentes sont magistrales, surtout pour jongler à deux massues. Je retenterai peut-être la semaine prochaine, mais je trouve les psychés difficiles mentalement quand il fait froid, surtout à jeun, et s'occuper d'un poêle à bois en plein trip, c'est la mort ^^°
Bravo à vous, vous m'avez bien saucé !
On est là pour ça. Pis franchement, si t'as les champis, l'harmaline, ou juste les graines de rue, sont pas bien compliquées à trouver, donc pas d'excuse, hop hop.
Quand on a rien dans l'ciboulot
autant y mettre un gros bédo
Hors ligne
https://www.fichier-pdf.fr/2012/06/04/jdc-damdam/
source: psychonaut
Dernière modification par Anonyme 239 (27 novembre 2023 à 02:05)
Hors ligne

- SillyCone

Ex-penseur de conscience
- 27 novembre 2023 à 16:53
Mezko a écrit
J'ai bazardé une grande partie du grain que j'avais lancé et j'en ai refait, dans une quantité plus limitée. Le gâchis me fait chier, mais j'étais dépassé par la place que ça allait prendre (mon autoclave de 23l était quasiment rempli jusqu'à ras bord). J'en ai relancé et j'ai pu faire 2 pots d'un litre, 2 pots de 1,5l et deux pots de 250ml (qui vont me permettre de tester mes CL, mais je crois qu'aucune n'est bonne. J'ai fini par mettre un des mycélium qui se développait bien dans l'agar mais qui, au bout d'une semaine, s'est avéré contaminé (à une distance raisonnable de la partie saine).
Rapidos, chaque volume a besoin d'un temps de stérilisation différent.
Je reposte ici ce que je t'ai envoyé en MP, ça servira à tout le monde :
En gros, le grain c'est :
500ml -> 60 minutes
1L -> 90 minutes
3L+ -> 150 minutes (dans les "spawn bags")
Si on stérilise le grain trop longtemps, il perd son eau et c'est trop sec pour les champis.
Et les CL et Agar (le liquide) et les instruments (scalpel, boite de petri, seringues, ...) c'est 20 minutes. Plus et la CL et agar caramélisent -> poubelle.
Dernière modification par SillyCone (27 novembre 2023 à 16:54)
Je ne réponds pas aux demandes d'information par MP.
Faites les en public que tout le monde puisse y répondre.
Gratitude
Hors ligne

- Mezko

Nouveau Psycho
- 28 novembre 2023 à 08:18
Doromo a écrit
C'est pas mal du tout. Après, vire le scotch, c'est typiquement le genre de truc qui va vibrer au niveau des coudes quand tu bosseras à l'intérieur, faisant entrer de l'air contaminé au moment même où tu réalises les actes à risques (ouverture de pot, découpe d'échantillon d'agar, etc). Arrange toi simplement pour que les ouvertures soient assez larges pour pouvoir travailler à l'intérieur sans frotter le plastique (des ouvertures) avec tes bras. La box permet de limiter les mouvements d'air par rapport à un travail à l'air libre, mais ce qui fait son efficacité, c'est les quelques secondes que tu prendras avant chaque geste risqué (pour laisser retomber les particules en suspension), la précision de tes gestes (le moins de mouvements inutiles possible, faire bien gaffe au placement de mains et des outils (éviter au maximum de se placer au dessus des pots et autres boites de pétri blabla)) ainsi que - et là c'est pour moi le gros avantage de la boite - la pellicule de liquide tapissant le plastique, laquelle piègera les nouveaux arrivants et leur évitera de rebondir vers tes champis (je pulvérise de l'eau savonneuse partout à l'intérieur à part au plafond, après la désinfection préparatoire, pour avoir une couche de gouttelettes fines qui me tiennent toute la séance). Et bien sûr, travaille le plus au fond de la boite possible.
Bien sûr, tout ça ne sert à rien si le grain ou l'agar n'a pas été suffisamment stérilisé, mais je ne t'apprends rien ^^
Scotch dégagé et je note toutes tes indications concernant les manoeuvres dans la boite. Et je n'avais pas du tout entendu parler de cette histoire d'eau savonneuse, tu le dilues à combien de % et sous quelle forme?
MERCI !
Doromo a écrit
On est là pour ça. Pis franchement, si t'as les champis, l'harmaline, ou juste les graines de rue, sont pas bien compliquées à trouver, donc pas d'excuse, hop hop.
Héhéhé, je suis patient ! Avant, rien ne pouvait durer plus de trois jours lorsqu'il tombait en ma possession, peu importe la quantité. Me suis calmé :p
SillyCone a écrit
Rapidos, chaque volume a besoin d'un temps de stérilisation différent.
Je reposte ici ce que je t'ai envoyé en MP, ça servira à tout le monde :
Image: https://www.psychoactif.org/forum/uploa … 859c6c.jpg
En gros, le grain c'est :
500ml -> 60 minutes
1L -> 90 minutes
3L+ -> 150 minutes (dans les "spawn bags")
Si on stérilise le grain trop longtemps, il perd son eau et c'est trop sec pour les champis.
Et les CL et Agar (le liquide) et les instruments (scalpel, boite de petri, seringues, ...) c'est 20 minutes. Plus et la CL et agar caramélisent -> poubelle.
Bon rappel, merci chef 
EDIT: quelqu'un connait les pan cyan Florida? Ou est ce que, comme les cubensis, un pan cyan est un pan cyan est un pan cyan? J'ai un bon d'achat (remboursement d'un kit à chier) et j'ai vu qu'ils étaient récemment apparus sur le site à Zorro. Et curiosité, naturellement.
Dernière modification par Mezko (28 novembre 2023 à 08:20)
*o*
Hors ligne
Mezko a écrit
Doromo a écrit
C'est pas mal du tout. Après, vire le scotch, c'est typiquement le genre de truc qui va vibrer au niveau des coudes quand tu bosseras à l'intérieur, faisant entrer de l'air contaminé au moment même où tu réalises les actes à risques (ouverture de pot, découpe d'échantillon d'agar, etc). Arrange toi simplement pour que les ouvertures soient assez larges pour pouvoir travailler à l'intérieur sans frotter le plastique (des ouvertures) avec tes bras. La box permet de limiter les mouvements d'air par rapport à un travail à l'air libre, mais ce qui fait son efficacité, c'est les quelques secondes que tu prendras avant chaque geste risqué (pour laisser retomber les particules en suspension), la précision de tes gestes (le moins de mouvements inutiles possible, faire bien gaffe au placement de mains et des outils (éviter au maximum de se placer au dessus des pots et autres boites de pétri blabla)) ainsi que - et là c'est pour moi le gros avantage de la boite - la pellicule de liquide tapissant le plastique, laquelle piègera les nouveaux arrivants et leur évitera de rebondir vers tes champis (je pulvérise de l'eau savonneuse partout à l'intérieur à part au plafond, après la désinfection préparatoire, pour avoir une couche de gouttelettes fines qui me tiennent toute la séance). Et bien sûr, travaille le plus au fond de la boite possible.
Bien sûr, tout ça ne sert à rien si le grain ou l'agar n'a pas été suffisamment stérilisé, mais je ne t'apprends rien ^^Scotch dégagé et je note toutes tes indications concernant les manoeuvres dans la boite. Et je n'avais pas du tout entendu parler de cette histoire d'eau savonneuse, tu le dilues à combien de % et sous quelle forme?
MERCI !Doromo a écrit
On est là pour ça. Pis franchement, si t'as les champis, l'harmaline, ou juste les graines de rue, sont pas bien compliquées à trouver, donc pas d'excuse, hop hop.
Héhéhé, je suis patient ! Avant, rien ne pouvait durer plus de trois jours lorsqu'il tombait en ma possession, peu importe la quantité. Me suis calmé :p
SillyCone a écrit
Rapidos, chaque volume a besoin d'un temps de stérilisation différent.
Je reposte ici ce que je t'ai envoyé en MP, ça servira à tout le monde :
Image: https://www.psychoactif.org/forum/uploa … 859c6c.jpg
En gros, le grain c'est :
500ml -> 60 minutes
1L -> 90 minutes
3L+ -> 150 minutes (dans les "spawn bags")
Si on stérilise le grain trop longtemps, il perd son eau et c'est trop sec pour les champis.
Et les CL et Agar (le liquide) et les instruments (scalpel, boite de petri, seringues, ...) c'est 20 minutes. Plus et la CL et agar caramélisent -> poubelle.Bon rappel, merci chef
EDIT: quelqu'un connait les pan cyan Florida? Ou est ce que, comme les cubensis, un pan cyan est un pan cyan est un pan cyan? J'ai un bon d'achat (remboursement d'un kit à chier) et j'ai vu qu'ils étaient récemment apparus sur le site à Zorro. Et curiosité, naturellement.
Oui moi prit un kit 1 fois, les pan cyan florida sont des copelandias de floride, ils sont un peu plus fin que les pan hawaiian, mais dedans ils contiennent plus de bleu que les hawaiian.
Hors ligne

- Mezko

Nouveau Psycho
- 30 novembre 2023 à 16:39
Petit point sur où j'en suis.
J'ai deux boites de pétri propres:


Je m'interroge sur la nécessité de mettre en pause la boite la plus avancée (frigo?) ou de la cloner dans un autre boite (je suis en attente de boites stériles).
J'avais une autre boite où une contamination commençait à apparaitre, loin du mycélium, je l'ai envoyé dans un petit pot de grains:

J'ai quatre gros pots de grains que j'ai mis au frigo en attentant de pouvoir les donner à manger au mycélium.
Et au final, j'ai commandé un kit de pan cyan Florida.
Parallèlement, j'ai bazardé toutes mes cultures liquides. Peut être un peu trop vite mais ça faisait un moment que je les avais lancées et elles étaient toutes assez troubles et je n'avais pas le sentiment qu'elles étaient bien parties. Je m'interroge sur la possibilité d'utiliser de l'eau en bouteille pour faire mes prochaines cultures liquides: l'eau de chez moi est très chargée en calcaire et je me retrouve toujours avec des dépôts au fond. Et ça m'empêche un peu de savoir si c'est du lard ou du cochon


*o*
Hors ligne

- SillyCone

Ex-penseur de conscience
- 01 décembre 2023 à 13:36
Doromo a écrit
SillyCone a écrit
La psilohuasca, pour moi, c'est le meilleur des 2 mondes : l'effet champi transformé par l'harmaline sans les effets vomitifs de la madre.
En vrai, je pense que c'est effectivement un excellent moyen de donner un aperçu de la DMT à une personne naïve en la matière, et pas forcément très aventureuse, surtout si elle est de base très peu douée avec un briquet.
Pas du tout d'accord, ayant initié un paquet de gens avec les 2, et pour plusieurs raisons. En vrac :
- Psilohuasca et DMT sont très différents au niveau des visions. Je connaissais bien les visions du champi quand j'ai goûté la DMT pour la première fois, et ce qui m'a bouleversé avec la DMT, c'est la présence d'êtres "sentients", d'"objets" et de lieux très caractéristiques. Avec le champi, c'était "ho la belle bleue", "les belles fractales", etc. Très joli mais pas ressenti comme ayant une existence "matérielle". Alors depuis que j'ai expérimenté avec la DMT, mes visions sous champis sont devenues plus "concrètes" et mieux définies, je reconnaissais clairement qu'on était dans la même famille de psychés (les tryptamines), et avec la psilohuasca, je pouvais plus interagir avec les visions comme je peux le faire sous DMT (en vocalisant, par exemple, je "crée" les visions), mais les visions restent très différentes.
- psilohuasca = 4 à 6h de trip, DMT = 5-10 minutes top. Quand j'ai quelqu'un qui panique sous DMT, j'ai juste à lui dire : "profite, dans 5 minutes top chrono c'est complètement fini". Sous psilohuasca, c'est 4h d'accompagnement avec le son pour en sortir...
Donc ouais, pour s'initier soi-même, la psilohuasca est plus facile techniquement, suffit de trouver les champis et l'harmaline et de gober le tout, mais faut gérer les 5h qui suivent, alors que la DMT est plus compliquée techniquement à faire tout seul sans expérience mais l'expérience elle-même est beaucoup plus gérable car très courte. (et puis si t'arrive pas à décoller, ben il se passe rien, alors qu'une fois que t'as avalé la psilohuasca, faut bien s'accrocher.)
Doromo a écrit
Et j'essayerai avec moins d'harmalas la prochaine fois, je tourne toujours entre 250 et 300 mg, et je pense qu'avec les 7 gr de psilos par dessus, c'est un poil trop intense pour moi par moments.
Par contre, les redescentes sont magistrales, surtout pour jongler à deux massues. Je retenterai peut-être la semaine prochaine, mais je trouve les psychés difficiles mentalement quand il fait froid, surtout à jeun, et s'occuper d'un poêle à bois en plein trip, c'est la mort ^^°



Waaaataaaaaaaa !
Tu m'étonnes...
Avec 300mg d'harmaline, je repeins les murs avec ma gerbe pendant 4h, et je tremble de partout pendant 8h de plus...
Et 7g de cubensis, ben j'ose même pas imaginer (avec 5g, je suis resté paralysé pendant 1h à pousser des râles), alors les 2 combinés...
Même avec 100mg, je vibre pendant 5h après que le champi soit descendu. Maintenant je tourne à 80mg. Juste assez pour potentialiser le champi sans sentir l'harmaline.
Doromo a écrit
Bravo à vous, vous m'avez bien saucé !
On est là pour ça. Pis franchement, si t'as les champis, l'harmaline, ou juste les graines de rue, sont pas bien compliquées à trouver, donc pas d'excuse, hop hop.
Hahahaha, clair ! Surtout que tu connais bien la madre, tu vas tout de suite reconnaître et kiffer la vibe, man, garanti !
Je ne réponds pas aux demandes d'information par MP.
Faites les en public que tout le monde puisse y répondre.
Gratitude
Hors ligne

- Doromo

Nouveau Psycho - 01 décembre 2023 à 19:19
Mezko a écrit
Et je n'avais pas du tout entendu parler de cette histoire d'eau savonneuse, tu le dilues à combien de % et sous quelle forme?
Je fais couler du liquide vaisselle cinq secondes dans la bouteille spray que je remplis d'eau. Je mélange et voilà. Honnêtement, je sais pas du tout si le liquide vaisselle a une réelle utilité : que ce soit l'exosporium des spores ou les parois de peptidoglycanes des bactéries, la couche extérieure de leurs cellules ne me semble pas être constituées d'une bicouche lipidique, mais bon, j'ai toujours eu la flemme de faire des recherches approfondies, et je me dis qu'un peu de produit chimique pour "assainir" l'eau elle même et piéger les quelques particules grasses qui voudront bien s'y coller, ça peut pas nuire. Et ça sent bon, en plus. Plus que la javel. Ça détruit moins les voies respiratoires, aussi, surtout après deux heures le nez devant la boite.
Sinon, je veux pas t'inquiéter et je sais très bien comment l'éclairage peut induire de fausses impressions à la photographie, mais je surveillerais de près mes pétri (la deuxième surtout) et le pot de grain.
Je m'interroge sur la possibilité d'utiliser de l'eau en bouteille pour faire mes prochaines cultures liquides: l'eau de chez moi est très chargée en calcaire et je me retrouve toujours avec des dépôts au fond. Et ça m'empêche un peu de savoir si c'est du lard ou du cochon hmm
De l'eau minérale ? Aucun souci. Certains disent d'éviter l'eau déminéralisée, mais c'est à peu près tout.
SillyCone a écrit
Je connaissais bien les visions du champi quand j'ai goûté la DMT pour la première fois, et ce qui m'a bouleversé avec la DMT, c'est la présence d'êtres "sentients", d'"objets" et de lieux très caractéristiques. Avec le champi, c'était "ho la belle bleue", "les belles fractales", etc. Très joli mais pas ressenti comme ayant une existence "matérielle"
C'est vrai, c'est d'ailleurs ce qui me rebute le plus avec les percées sous DMT, cet aspect hyperréel où les visions, même purement géométriques et architecturales, ont clairement des intentions (elles ne m'ont jamais parlé, mais elles étaient sentientes et quelque peu invasives). Même à dose raisonnable à la changa (alors que je vis toujours des expériences super comme ça), ça me demande une loooongue préparation mentale, et il me faut plusieurs jours pour digérer ensuite, surtout les visions intérieures qui sont certes magnifiques, mais très unheimlich parfois, au sens strict et premier du terme.
C'est pour ça que je pensais la psilohuasca comme un pont entre les deux mondes, mais effectivement davantage pour un consommateur habitué aux champis mais encore réticent à tenter l'aller direct vers le DMT-verse, ou même moins direct via changa.
Avec 300mg d'harmaline, je repeins les murs avec ma gerbe pendant 4h, et je tremble de partout pendant 8h de plus...
Et 7g de cubensis, ben j'ose même pas imaginer (avec 5g, je suis resté paralysé pendant 1h à pousser des râles), alors les 2 combinés...
Même avec 100mg, je vibre pendant 5h après que le champi soit descendu. Maintenant je tourne à 80mg. Juste assez pour potentialiser le champi sans sentir l'harmaline.
Tu fais bien de me rappeler qu'on réagit tous différemment, je ferai d'autant plus attention aux doses quand j'initierai mes amis. Après, même comme ça, ça reste gérable, juste un peu longuet dans les passages type "eh connard, regarde, une montagne d'émotion qui moisissent depuis des lustres sous le tapis, ressens les, ressens les toutes en même teeeeemps sur fond de visions anxiogènes, wouh".
En revanche, deux pauvres grammes de mimosa bouilli en accompagnement de ma tisane de rue (légère), et je me retrouve à combattre la nausée pendant des heures.
Ah, d'ailleurs, vous trouvez que les psychés vous rendent plus sensibles (psychologiquement) aux bobos physiques, ou juste à l'inconfort en général (un peu trop chaud un peu trop froid y a faim tout ça) ? A part aux tensions de mes tendinoses qui rodent, je suis vraiment pas très sensible aux signaux corporels en temps normal, mais alors sous champi surtout, qu'est-ce que mon imagination devient douillette @_@
Dernière modification par Doromo (01 décembre 2023 à 19:26)
Quand on a rien dans l'ciboulot
autant y mettre un gros bédo
Hors ligne

- SillyCone

Ex-penseur de conscience
- 02 décembre 2023 à 02:03
Doromo a écrit
C'est vrai, c'est d'ailleurs ce qui me rebute le plus avec les percées sous DMT, cet aspect hyperréel où les visions, même purement géométriques et architecturales, ont clairement des intentions (elles ne m'ont jamais parlé, mais elles étaient sentientes et quelque peu invasives). Même à dose raisonnable à la changa (alors que je vis toujours des expériences super comme ça), ça me demande une loooongue préparation mentale, et il me faut plusieurs jours pour digérer ensuite, surtout les visions intérieures qui sont certes magnifiques, mais très unheimlich parfois, au sens strict et premier du terme.
Ah carrément ! Qu'est-ce qu'ils me veulent, ces trucs ?
Pourquoi il me regarde comme ça, le bonhomme allumette iridisé en titanium perché sur son manège qui fait dling dling ?
"Dis, co-pilote, ça a duré combien de temps ce voyage pendant lequel une tête d'entité géante (au moins 10m de haut) a ouvert la bouche pour me déverser un flux géant d'informations couleur arc-en-ciel ? 20 minutes ? Une demi-heure ? Quoi ???? 5 minutes ??? Naaaaaaaaan ! 5 minutes ? 5 minutes ??? T'es sûr ? 5 minutes ? 5 minutes ? 5 minutes ? 5 PUTAINS DE MINUTES ?"
Un jour, j'ai réussi à y aller avec le coeur ouvert, et les entités sont devenues bienveillantes instantanément.
Ce qui n'empêche que c'est tellement unheimlich (merci pour le mot, c'est exactement ce que je ressens) que ça fait des années que j'y suis pas retourné, et que sous ayahuasca en général, je coupe les visions. La dernière fois, il m'ont bien expliqué que l'illusion c'était la matière, et que le réel était là haut (ou en diagonale plutôt  ) avec eux...
) avec eux...
Je verrai bien tout ça quand je serai mort...
Doromo a écrit
Tu fais bien de me rappeler qu'on réagit tous différemment, je ferai d'autant plus attention aux doses quand j'initierai mes amis.
Ah oui, fondamental !
D'un autre côté, parfois y faut y aller, parce qu'ils sont tellement barrés dans le mental qu'il faut une dose suffisante pour les faire lâcher prise...
Harmaline HCl : 100mg, cubensis secs : entre 2 et 4g. 5g sur demande pour ceux qui sont déjà passé par là et qui savent ce qu'ils veulent (et sont prêt à vivre les conséquences de leur choix sans pleurer leur mère en position foetale...)
N'oublions pas que Terrence McKenna lui même considérait 5g comme étant une dose héroïque, alors qu'il a passé des mois sous cubensis quasi de manière ininterrompue au Brésil avec son frangin Dennis.
Donc ta tolérance à 7g est extrêmement rare. J'en ai croisé que 2-3 maximum capable de tenir ces doses, et le plus souvent ils avaient un passé de dépendance aux opiacés qui les ont apparemment un tantinet insensibilisé.
Donc fait gaffe sous peine de finir aux urgences avec tes amis qui décompressent...
Doromo a écrit
En revanche, deux pauvres grammes de mimosa bouilli en accompagnement de ma tisane de rue (légère), et je me retrouve à combattre la nausée pendant des heures.
Ça ce sont probablement les tanins du mimosa, rien à voir avec le côté vomitif des harmalas.
Y a des recettes pour les enlever (avec du blanc d'oeuf) mais c'est trop chiant donc pour moi, mimosa-> extraction DMT, ayahuasca <- chacruna.
Doromo a écrit
Ah, d'ailleurs, vous trouvez que les psychés vous rendent plus sensibles (psychologiquement) aux bobos physiques, ou juste à l'inconfort en général (un peu trop chaud un peu trop froid y a faim tout ça) ? A part aux tensions de mes tendinoses qui rodent, je suis vraiment pas très sensible aux signaux corporels en temps normal, mais alors sous champi surtout, qu'est-ce que mon imagination devient douillette @_@
Ah ben oui... C'est pour ça que je porte une attention toute particulière au confort physique de mes participants. "Ça va les enfants, bien installés ?" Ok, c'est parti, un pti coup de gong, et hop, ils remplissent les bassines 
Dernière modification par SillyCone (02 décembre 2023 à 02:08)
Je ne réponds pas aux demandes d'information par MP.
Faites les en public que tout le monde puisse y répondre.
Gratitude
Hors ligne
 . Le reste des ingrédients obligé de steriliser.
. Le reste des ingrédients obligé de steriliser.
Dernière modification par Anonyme 239 (02 décembre 2023 à 02:35)
Hors ligne

- SillyCone

Ex-penseur de conscience
- 02 décembre 2023 à 02:43
Anonyme 239 a écrit
Je vais essayer de faire une grande barquette de copelandia, je vais pas me faire ch*er, seringue de spore neuve, et cereale dans un plastique deja sterilisé par le marchant en labo avec port d'injection
. Le reste des ingrédients obligé de steriliser.
Le problème du copelandia, ce n'est pas la phase du grain, mais la suivante car il faut mélanger ton grain colonisé avec du crotin (stérilisé bien entendu) et recouvrir le tout d'une couche de tourbe noire pasteurisée.
Bref, c'est bien compliqué et virtuellement impossible sans une belle expérience en mycologie.
Je t'invite plutôt à en rester au cubensis si tu veux faire ça à l'arrache.
Ainsi que de créer ton propre fil pour ne pas hacker celui de Mezko.
Je ne réponds pas aux demandes d'information par MP.
Faites les en public que tout le monde puisse y répondre.
Gratitude
Hors ligne
SillyCone a écrit
Anonyme 239 a écrit
Je vais essayer de faire une grande barquette de copelandia, je vais pas me faire ch*er, seringue de spore neuve, et cereale dans un plastique deja sterilisé par le marchant en labo avec port d'injection
. Le reste des ingrédients obligé de steriliser.
Le problème du copelandia, ce n'est pas la phase du grain, mais la suivante car il faut mélanger ton grain colonisé avec du crotin (stérilisé bien entendu) et recouvrir le tout d'une couche de tourbe noire pasteurisée.
Bref, c'est bien compliqué et virtuellement impossible sans une belle expérience en mycologie.
Je t'invite plutôt à en rester au cubensis si tu veux faire ça à l'arrache.
Ainsi que de créer ton propre fil pour ne pas hacker celui de Mezko.
pas faire à l'arrache mais pas m'embêter a faire une empreinte de spore, une seringue deja faite chez le marchant, et du grain deja achete sterilisé, biensur dans les regles de l'art de propreté hygiène, alcool 70 iso à fond^^.
Dernière modification par Anonyme 239 (02 décembre 2023 à 03:02)
Hors ligne

- Mezko

Nouveau Psycho
- 02 décembre 2023 à 09:33
Et je sais que si je mélange trop d'infos en même temps, ça ne donne rien.
Doromo: je pense que ce dont tu me mets en garde sur la boite de pétri, ce sont des bulles d'air. Je garde un bon oeil dessus. Le pot de grains me semble bien parti, mais même topo: je surveille.
Je pense qu'il me faut un vrai incubateur, et je me tâte sur comment gérer ça. Pour le moment, c'est un peu posé sur ma table basse de salon avec un petit soufflant qui se déclenche ponctuellement (d'où la condensation dans le pot et les boites). La température n'est pas optimale (entre 20 et 23°, voire un peu plus quand le soufflant se déclenche) et je ne sais pas trop comment m'organiser: entre mon étage où la température est glaciale en période froide et le bas qui retient bien la chaleur mais dont la fenêtre doit rester ouverte en journée quand on bosse tous les deux (fucking cats), c'est complicado. J'ai un tapis chauffant que je pourrais placer sous une boite du même type que ma SAB, voire dans la SAB. Qu'en pensez vous chers messieurs?
Autre interrogation: que se passe-t-il quand le mycélium a colonisé toute ma boite de pétri? Je clone? J'envoie dans le grain? Les deux? ^^
Danke schoen et bon week end à vous !
*o*
Hors ligne

- Doromo

Nouveau Psycho - 02 décembre 2023 à 13:08
SillyCone a écrit
"Dis, co-pilote, ça a duré combien de temps ce voyage pendant lequel une tête d'entité géante (au moins 10m de haut) a ouvert la bouche pour me déverser un flux géant d'informations couleur arc-en-ciel ?
xD Ouais, c'est des expériences de dingue, mais pas les plus faciles à intégrer, pour sûr.
J'en ai croisé que 2-3 maximum capable de tenir ces doses, et le plus souvent ils avaient un passé de dépendance aux opiacés qui les ont apparemment un tantinet insensibilisé.
Intéressant, ça. J'aurais pensé que c'était plus commun que ça, cela dit, vu le nombre qui relatent leurs expériences régulières à 7g++ sur les toâles, mais c'est surement en partie de la frime mal placée, ou un biais de survivance.
Ça ce sont probablement les tanins du mimosa, rien à voir avec le côté vomitif des harmalas.
Yep, je filtre bien et je lie les tanins avec deux blancs d'œufs, mais même comme ça, c'est blurk. Je me sentirai jamais capable de tenter l'expérience aya à dose traditionnelle, je crois, et c'est bien dommage (d'autant qu'il faut sacrément monter les doses de dmt (pas freebase bien sûr) en pharmahuasca pour commencer à avoir un effet, je trouve).
Chais pas comment vous faites vous autres les téméraires du bidou.
"Ah ben oui... C'est pour ça que je porte une attention toute particulière au confort physique de mes participants. "Ça va les enfants, bien installés ?" Ok, c'est parti, un pti coup de gong, et hop, ils remplissent les bassines"
Et jaillissez fontaines ! Tu vas jamais les promener en forêt ou du moins en montagnes pelées, tes participants ? Je me doute que ce serait giga risqué et pas du tout pratique pour le déroulé de la cérémonie, mais tu dois forcément en avoir parfois qui deviennent claustro à rester relativement immobiles en intérieur, non ?
Un jour, j'ai réussi à y aller avec le coeur ouvert, et les entités sont devenues bienveillantes instantanément.
Bonne idée, je vais travailler mon ouverture cardiaque en attendant le printemps psychédélique prochain, ça me donnera une raison tangible et personnellement utile de me mettre à ce genre de méditation.
Merci pour les conseils de dosage sinon, je m'y tiendrai prudemment, pas envie de traumatiser mes potes, ni d'attirer les képis.
Mezko a écrit
Doromo: je pense que ce dont tu me mets en garde sur la boite de pétri, ce sont des bulles d'air.
Je pensais aux taches gris-verdâtres dans le mycélium, et à l'aspect cotoneux-mou du mycélium du pot, associé à l'aspect humide gluant du grain, mais d'une, je connais pas les copélandias, et de deux, ça pourrait tout autant être des ombres et un léger excédent de condensation.
Qu'en pensez vous chers messieurs?
Ah, les problèmes logistiques en myco, un bonheur sans cesse renouvelé. Je dirais que ça dépend des quantités que tu veux y caser, surtout. J'ai jamais réussi à maintenir les températures idoines avec un tapis, perso, mais j'ai très bien réussi à maintenir du 20° en fin d'hiver dans un gros incubateur double-boites à eau + chauffage d'aquarium 100w (je crois) à 20 balles. Dès que les températures ambiantes remontent à 19°, je remets tout sur des étagères.
Autre interrogation: que se passe-t-il quand le mycélium a colonisé toute ma boite de pétri? Je clone? J'envoie dans le grain? Les deux? ^^
Y a pas de limites, Mymy se décline à l'infini (ou presque). Tu peux faire tout ça, tu peux aussi le laisser trainer au chaud un mois ou deux jusqu'à voir y pousser des primordia, que tu peux alors scalpeler et reposer sur agar pour faire repartir du mycélium de survivaliste déter.
Quand on a rien dans l'ciboulot
autant y mettre un gros bédo
Hors ligne

- SillyCone

Ex-penseur de conscience
- 02 décembre 2023 à 13:11
Mezko a écrit
Ralala, va falloir que je me pose pour bien ingérer toutes vos infos sur le psilohuasca !
Et je sais que si je mélange trop d'infos en même temps, ça ne donne rien.
Les infos, c'est pour la tête, la psilohuasca, c'est pour le coeur.
Donc tu nous avale tout ça fissa et pis c'est TOUT ! 
100mg d'harmalas HCl extraite, 30 minutes plus tard, ta dose usuelle de champis (éventuellement à la baisse pour tester le combo).
À partir de là, tu auras un point de comparaison et tu adaptes selon l'envie.
Mezko a écrit
Je pense qu'il me faut un vrai incubateur, et je me tâte sur comment gérer ça. [...] Qu'en pensez vous chers messieurs?
Autre interrogation: que se passe-t-il quand le mycélium a colonisé toute ma boite de pétri? Je clone? J'envoie dans le grain? Les deux? ^^
Danke schoen et bon week end à vous !
Bitte schoen ! (j'adore dire ça  )
)
Alors, incubateur... Faudrait que je fasse un tuto, mais rapidos :
2 ou 3 grands bacs plastique identiques, 1 couvercle, 1 chauffage d'aquarium (aquariuuuu-uuuuum, peace), et un thermostat-relais STC-1000 (quelques roros sur e**y).
Le chauffage d'aquarium dans le premier bac, avec quelques centimètres d'eau (bien couvrir la résistance + une bonne marge), le deuxième bac dans le premier, la sonde de température dans le deuxième bac avec tout ce que tu veux incuber + couvercle.
Chauffage branché sur le relais de chauffage du thermostat, température réglée sur 28°C avec un delta de 2-3°C.
Y a plus qu'à regarder ses pots d'1L coloniser en 6-7 jours.


Pour la petri, une fois colonisé, tu peux cloner pour produire plus d'agar2grain, mettre au frigo pour préserver ou mettre dans le grain... Ça dépend pourquoi t'as fait de l'agar pour commencer 
Je ne réponds pas aux demandes d'information par MP.
Faites les en public que tout le monde puisse y répondre.
Gratitude
Hors ligne

- Mezko

Nouveau Psycho
- 02 décembre 2023 à 13:47
Pour l'agar, c'était pour lancer les spores, deux boites sur 20 ont survécu. Mais je pense que je vais me servir de la zolie boite bien développée pour aller dans les grands pots de grain, et probablement la cloner avec mon prochain arrivage de boites stériles. Vu que je débute, je teste et tatônne, plutôt content du résultat jusque-là !
Pour le peganum, ça va venir, ça va venir ! Je bosse avec lui en ce moment:

Et ça déconne zéro !
PS: on conjure le mal en parlant allemand. T'habites à Bitte?
*o*
Hors ligne
SillyCone a écrit
Le problème du copelandia, ce n'est pas la phase du grain, mais la suivante car il faut mélanger ton grain colonisé avec du crotin (stérilisé bien entendu) et recouvrir le tout d'une couche de tourbe noire pasteurisée.
Bref, c'est bien compliqué et virtuellement impossible sans une belle expérience en mycologie.
Toi tu avais essayer cette espèce il y a une dizaine d'années, tu avais moins d'expériences que maintenant, j'espère qu'un jour tu recommenceras de le faire.
Dernière modification par Stelli (02 décembre 2023 à 23:05)
Hors ligne
Dernière modification par Anonyme 239 (02 décembre 2023 à 23:42)
Hors ligne
- anonyme 87

Nouveau Psycho
- 02 décembre 2023 à 17:56
Ps : Merci d'arrêter de quote tout un post quand tu réponds parce que ça rend la lecture des topics difficile pour les utilisateurs (Le principe d'un forum c'est que chacun puisse se lire et interagir de manière compréhensible)
Dernière modification par anonyme 87 (02 décembre 2023 à 17:57)
Hors ligne

- Mezko

Nouveau Psycho
- 02 décembre 2023 à 17:59
Bref, on a dépassé le stade de la relouitude depuis UN BAIL.
*o*
Hors ligne

- Mezko

Nouveau Psycho
- 05 décembre 2023 à 12:22

Est ce que c'est craignos? Ca m'ennuierait de gâcher mes boites de pétri toutes neuves.
Sinon, transferts de ma jolie plaque toute propre dans les pots ce matin.
Je vais tenter la technique de Sillycone pour récupérer du mycélium dans le petit pot que j'ai posté plus haut (ça s'est bien développé) en y injectant de la CL vierge et la resucer pour la rebalancer dans d'autres pots de CL.
Grosses manoeuvres !
EDIT: tout est lancé ^^
J'ai, en plus, mis quelques gouttes d'une seringue de spores dans deux boites de pétri, j'aimerais bien pouvoir en faire partir aussi.
Dernière modification par Mezko (05 décembre 2023 à 14:18)
*o*
Hors ligne
Sujets similaires dans les forums, psychowiki et QuizzZ
» Empreinte de spores Copelandia
Affichage Bureau - A propos de Psychoactif - Politique de confidentialité - CGU - Contact -

 1, 2776 vues, dernier message :
1, 2776 vues, dernier message :  Soutenez PsychoACTIF
Soutenez PsychoACTIF